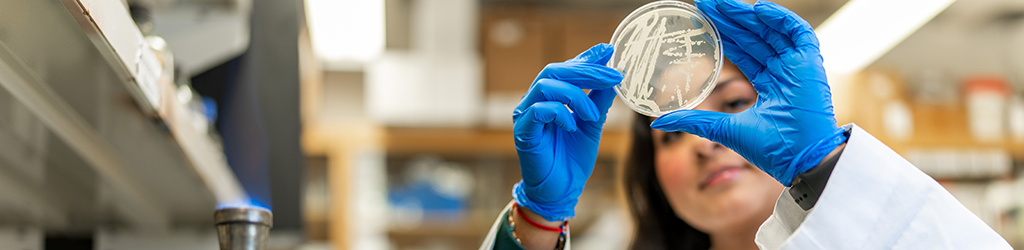

- Apply Today: Undergraduate
- Apply Today: Graduate
Academic Advising - Diversity and Inclusion Statement
- Majors & Minors
- A&S Academic Departments
CONTACT
Klingler College of Arts and Sciences
Sensenbrenner Hall
1103 W. Wisconsin Ave.
Milwaukee, WI 53233
(414) 288-7059
ARTS & SCIENCES ON SOCIAL




PROBLEM WITH THIS WEBPAGE?
Report an accessibility problem
To report another problem, please contact kirsten.boeh@marquette.edu.